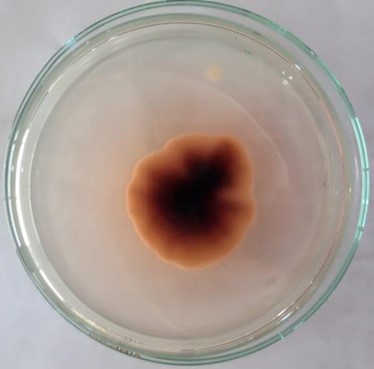
Hasil Makroskopis Jamur Trichophyton rubrum

Aktivitas Antijamur Ekstrak Etanolik Daun Berenuk (Crescentia cujete, Linn.) terhadap Trichophyton rubrum
DOI:
https://doi.org/10.31001/cihams.v1i.2Keywords:
ekstrak daun berenuk, antijamur, Trichophyton rubrumAbstract
Daun Berenuk (Cresentia cujete, Linn) merupakan salah satu tanaman herbal yang dapat dimanfaatkan sebagai antijamur. Daun Berenuk diketahui mengandung senyawa flavonoid, alkaloid, saponin, tanin, dan fenol. Tujuan penelitian ini ialah untuk mengetahui adanya aktivitas antijamur ekstrak daun berenuk (Crescentia cujete, Linn.) dalam menghambat pertumbuhan Trichophyton rubrum. Daun Berenuk yang diperoleh di daerah Juwiring, Klaten. Daun yang diambil adalah daun yang tidak terlalu muda dan tidak terlalu tua. Serbuk daun berenuk diekstraksi dengan metode maserasi menggunakan pelarut etanol 70%. Ekstrak kemudian ditambah DMSO 2% pada masing-masing konsentrasi 10%, 20%, 30%, 40%, dan 50%. Metode pengujian aktivitas antijamur dengan metode difusi paper disk. Hasil pengujian dianalisis dengan uji Anova (One Way Anova). Hasil penelitian menunjukkan bahwa ekstrak daun berenuk mempunyai aktivitas antijamur terhadap Trichophyton rubrum. Rata-rata diameter zona hambat ekstrak daun berenuk pada konsentrasi 10%, 20%, 30%, 40%, dan 50% adalah 13,8; 15,3; 16,3; 17,3; 19,3. Konsentrasi yang paling efektif dalam menghambat Trichophyton rubrum terdapat pada konsentrasi 50%.